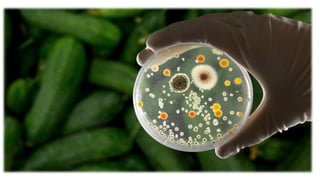

La microbiologie alimentaire étudie les microorganismes qui affectent les aliments, distinguant les flores indésirables des flores utiles. Différentes méthodes de conservation, telles que la pasteurisation, le froid et d'autres techniques, visent à préserver les qualités organoleptiques des denrées et à freiner le développement microbien. Le document aborde également des processus de fermentation et les conditions nécessaires à la conservation des aliments.